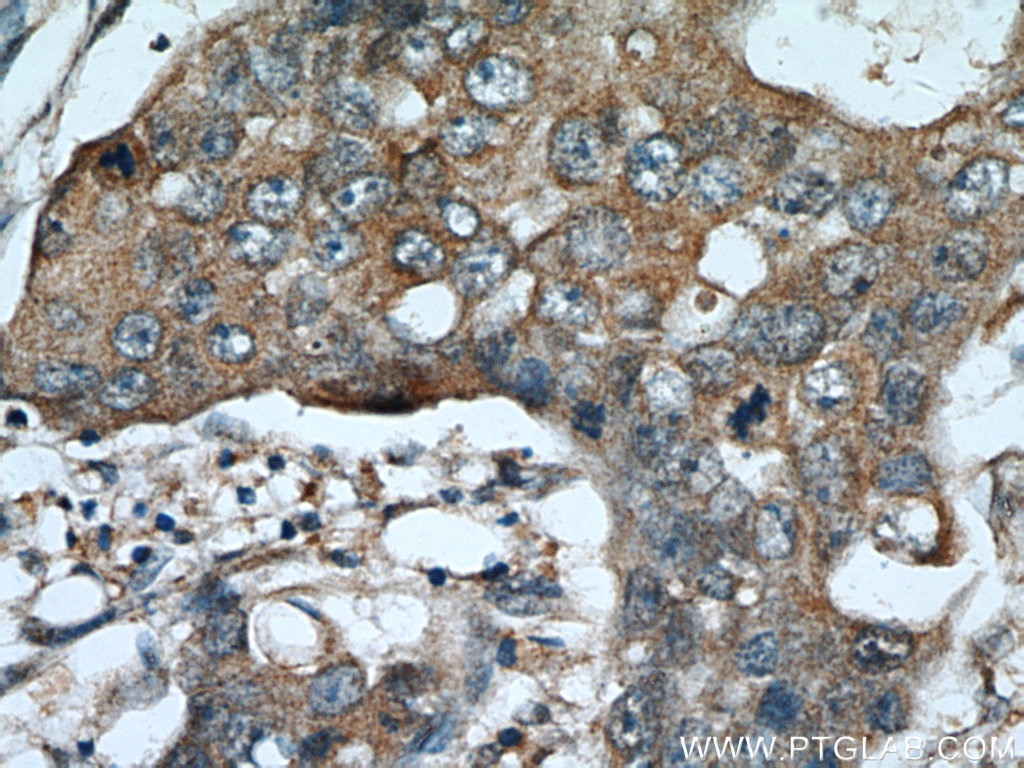
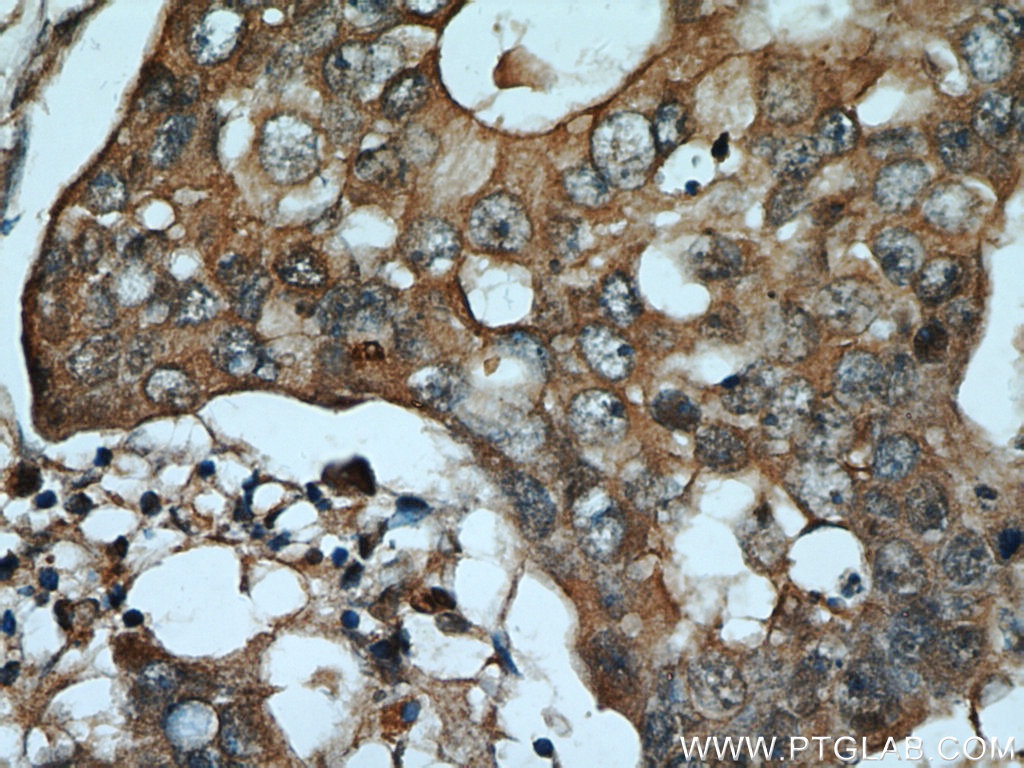

验证数据展示
经过测试的应用
| Positive WB detected in | mouse brain tissue, HeLa cells, mouse heart tissue, rat brain tissue, MCF-7 cells |
| Positive IP detected in | HeLa cells |
| Positive IHC detected in | human placenta tissue, human breast cancer tissue Note: suggested antigen retrieval with TE buffer pH 9.0; (*) Alternatively, antigen retrieval may be performed with citrate buffer pH 6.0 |
| Positive IF/ICC detected in | HepG2 cells |
| Positive FC (Intra) detected in | HeLa cells |
推荐稀释比
| 应用 | 推荐稀释比 |
|---|---|
| Western Blot (WB) | WB : 1:500-1:2000 |
| Immunoprecipitation (IP) | IP : 0.5-4.0 ug for 1.0-3.0 mg of total protein lysate |
| Immunohistochemistry (IHC) | IHC : 1:50-1:500 |
| Immunofluorescence (IF)/ICC | IF/ICC : 1:200-1:800 |
| Flow Cytometry (FC) (INTRA) | FC (INTRA) : 0.25 ug per 10^6 cells in a 100 µl suspension |
| It is recommended that this reagent should be titrated in each testing system to obtain optimal results. | |
| Sample-dependent, Check data in validation data gallery. | |
产品信息
14139-1-AP targets ADAM12 in WB, IHC, IF/ICC, FC (Intra), IP, ELISA applications and shows reactivity with human, mouse, rat samples.
| 经测试应用 | WB, IHC, IF/ICC, FC (Intra), IP, ELISA Application Description |
| 文献引用应用 | WB, IHC, IF, IP |
| 经测试反应性 | human, mouse, rat |
| 文献引用反应性 | human, mouse, rat |
| 免疫原 |
CatNo: Ag5206 Product name: Recombinant human ADAM12 protein Source: e coli.-derived, PGEX-4T Tag: GST Domain: 31-350 aa of BC060804 Sequence: VSLWNQGRADEVVSASVRSGDLWIPVKSFDSKNHPEVLNIRLQRESKELIINLERNEGLIASSFTETHYLQDGTDVSLARNYTGHCYYHGHVRGYSDSAVSLSTCSGLRGLIVFENESYVLEPMKSATNRYKLFPAKKLKSVRGSCGSHHNTPNLAAKNVFPPPSQTWARRHKRETLKATKYVELVIVADNREFQRQGKDLEKVKQRLIEIANHVDKFYRPLNIRIVLVGVEVWNDMDKCSVSQDPFTSLHEFLDWRKMKLLPRKSHDNAQLVSGVYFQGTTIGMAPIMSMCTADQSGGIVMDHSDNPLGAAVTLAHELG 种属同源性预测 |
| 宿主/亚型 | Rabbit / IgG |
| 抗体类别 | Polyclonal |
| 产品类型 | Antibody |
| 全称 | ADAM metallopeptidase domain 12 |
| 别名 | ADAM 12, Disintegrin and metalloproteinase domain-containing protein 12, EC:3.4.24.-, MCMP, Meltrin-alpha |
| 计算分子量 | 100 kDa |
| 观测分子量 | 90-100 kDa, 70-80 kDa |
| GenBank蛋白编号 | BC060804 |
| 基因名称 | ADAM12 |
| Gene ID (NCBI) | 8038 |
| RRID | AB_2289230 |
| 偶联类型 | Unconjugated |
| 形式 | Liquid |
| 纯化方式 | Antigen affinity purification |
| UNIPROT ID | O43184 |
| 储存缓冲液 | PBS with 0.02% sodium azide and 50% glycerol, pH 7.3. |
| 储存条件 | Store at -20°C. Stable for one year after shipment. Aliquoting is unnecessary for -20oC storage. |
背景介绍
ADAM12, also named as MLTN and Meltrin-alpha, is involved in skeletal muscle regeneration, specifically at the onset of cell fusion. It is also involved in macrophage-derived giant cells (MGC) and osteoclast formation from mononuclear precursors. ADAM12 is expressed in human malignant tumors(PMID:17355265). ADAM12's ability to degrade extracellular matrix components likely allows it to detach cancer cells from the basement membrane and assist them on their route to metastasis. But the protein's role not just as a biomarker of breast cancer but as a gateway to cancer cell migration is only now being understood. ADAM12 has 2 isoforms with the calculated molecular mass of 100 and 80 kDa, and this antibody can recognize all isoforms of ADAM12. ADAM12 has 4 forms: 120kDa full-length form, 90kd mature (processed form that lack the prodomain), 50-68kDa degradation product and 27kDa prodomain.
实验方案
| Product Specific Protocols | |
|---|---|
| FC protocol for ADAM12 antibody 14139-1-AP | Download protocol |
| IF protocol for ADAM12 antibody 14139-1-AP | Download protocol |
| IHC protocol for ADAM12 antibody 14139-1-AP | Download protocol |
| IP protocol for ADAM12 antibody 14139-1-AP | Download protocol |
| WB protocol for ADAM12 antibody 14139-1-AP | Download protocol |
| Standard Protocols | |
|---|---|
| Click here to view our Standard Protocols |
发表文章
| Species | Application | Title |
|---|---|---|
Cell Stem Cell Vaccination-based immunotherapy to target profibrotic cells in liver and lung | ||
J Cell Biol Notch increases the shedding of HB-EGF by ADAM12 to potentiate invadopodia formation in hypoxia. | ||
Matrix Biol Antibodies and methods for immunohistochemistry of extracellular matrix proteins. | ||
Theranostics Dysregulation of interaction between LOXhigh fibroblast and smooth muscle cells contributes to the pathogenesis of aortic dissection. | ||
Cell Death Differ ADAM12-directed ectodomain shedding of E-cadherin potentiates trophoblast fusion. | ||
J Hematol Oncol Aspartate β-hydroxylase promotes pancreatic ductal adenocarcinoma metastasis through activation of SRC signaling pathway. |